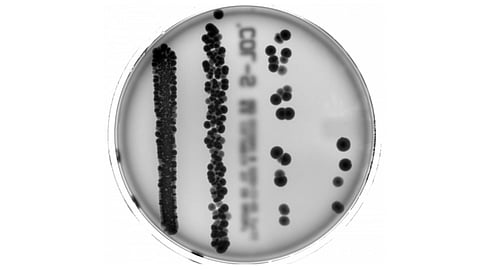

When parts of the liver are removed, the body can replace the missing tissue. A team of researchers at the Technical University of Munich (TUM) has now discovered that the success of this process depends to a large extent on gut bacteria. The results of the study could help to improve the prognosis after liver surgery in case of liver cancer and other diseases.
The human liver has an astonishing ability to regenerate, unlike the heart, for example. The underlying biological mechanisms are an example of the role played by our gut bacteria in processes taking place in other organs. This is demonstrated in new research conducted by an interdisciplinary team from the TUM University Hospital Klinikum rechts der Isar and the TUM School of Life Sciences.
Short-chain fatty acids needed for growth
A healthy gut microbiome consists of many types of bacteria. They play an active role in digestion. Some of them break down carbohydrates into short-chain fatty acids (SCFAs), for example. “Liver cells need these fatty acids to grow and divide,” says study leader Prof. Klaus-Peter Janssen from the Department of Surgery of the Klinikum rechts der Isar. “We have now succeeded in showing for the first time that gut bacteria influence the lipid metabolism in liver cells, and therefore their ability to regenerate.”
Antibiotics stop liver regeneration
Prof. Janssen and his team conducted experiments on mice to determine how a disrupted microbiome affects liver regeneration. In animals in which the microbiome was perturbed through antibiotics, formation of new liver cells was strongly delayed. Scientists were already aware of a link between antibiotics and disrupted liver regeneration. However, this was previously attributed to the body’s immune response or harmful side effects of antibiotics on liver cells, explains Klaus-Peter Janssen. The mechanistic connection to gut bacteria only came to light in the TUM study. In accordance to mice treated with antibiotics, liver cells were also not regenerated in mice lacking a microbiome already at birth.
“Microbiome starter set” activates liver cell growth
“Antibiotics do not kill all gut bacteria,” explains Anna Sichler, one of the two first authors of the study. “However, the medication changes the composition of the microbiome: the remaining bacteria species produce far fewer short-chain fatty acids.” The microbiome usually recovers within a few weeks of the antibiotic treatment. The current study showed that liver regeneration also occurred in animals treated with antibiotics, but with a significant delay. In mice lacking gut bacteria, no regeneration took place. However, the researchers were able to stimulate liver regeneration by treating them with a precisely defined “microbiome starter set”.
Experiments with organoids and human cells
Using organoids made up of mouse cells – essentially miniature livers in a Petri dish– the researchers demonstrated that SCFAs provide essential building blocks for the cell membrane in liver cells. If SCFAs are not present in sufficient quantities, the cells refuse to grow and multiply. When the cells multiplied because enough fatty acids are available, the team found that an enzyme known as SCD1 was especially active. “We then investigated the processes with human liver cells and tissue samples,” says Yuhan Yin, who is also a first author of the study. “SCD1 is also active in humans when the liver regenerates.”
Possible applications before and after surgery
“It is important to bear in mind that the role of gut bacteria in our bodies is highly complex. We have a long way to go before we fully understand it,” says Klaus-Peter Janssen. Therefore, the study does not offer specific recommendations for further action or the development of drugs. “However, our results could be used for new research into which microbiome compositions offer better conditions for liver regeneration.” Physicians could then examine patients’ gut bacteria to determine whether conditions are favorable for surgery or whether it is better to wait for the microbiome to recover.” It might also be possible to influence recovery with a certain diet.
“And conversely, physicians might also be able to examine the microbiome through stool samples to determine how well the liver is regenerating after an operation,” says Prof. Janssen. This question will be the subject of further studies by the team. (MSM/Newswise)